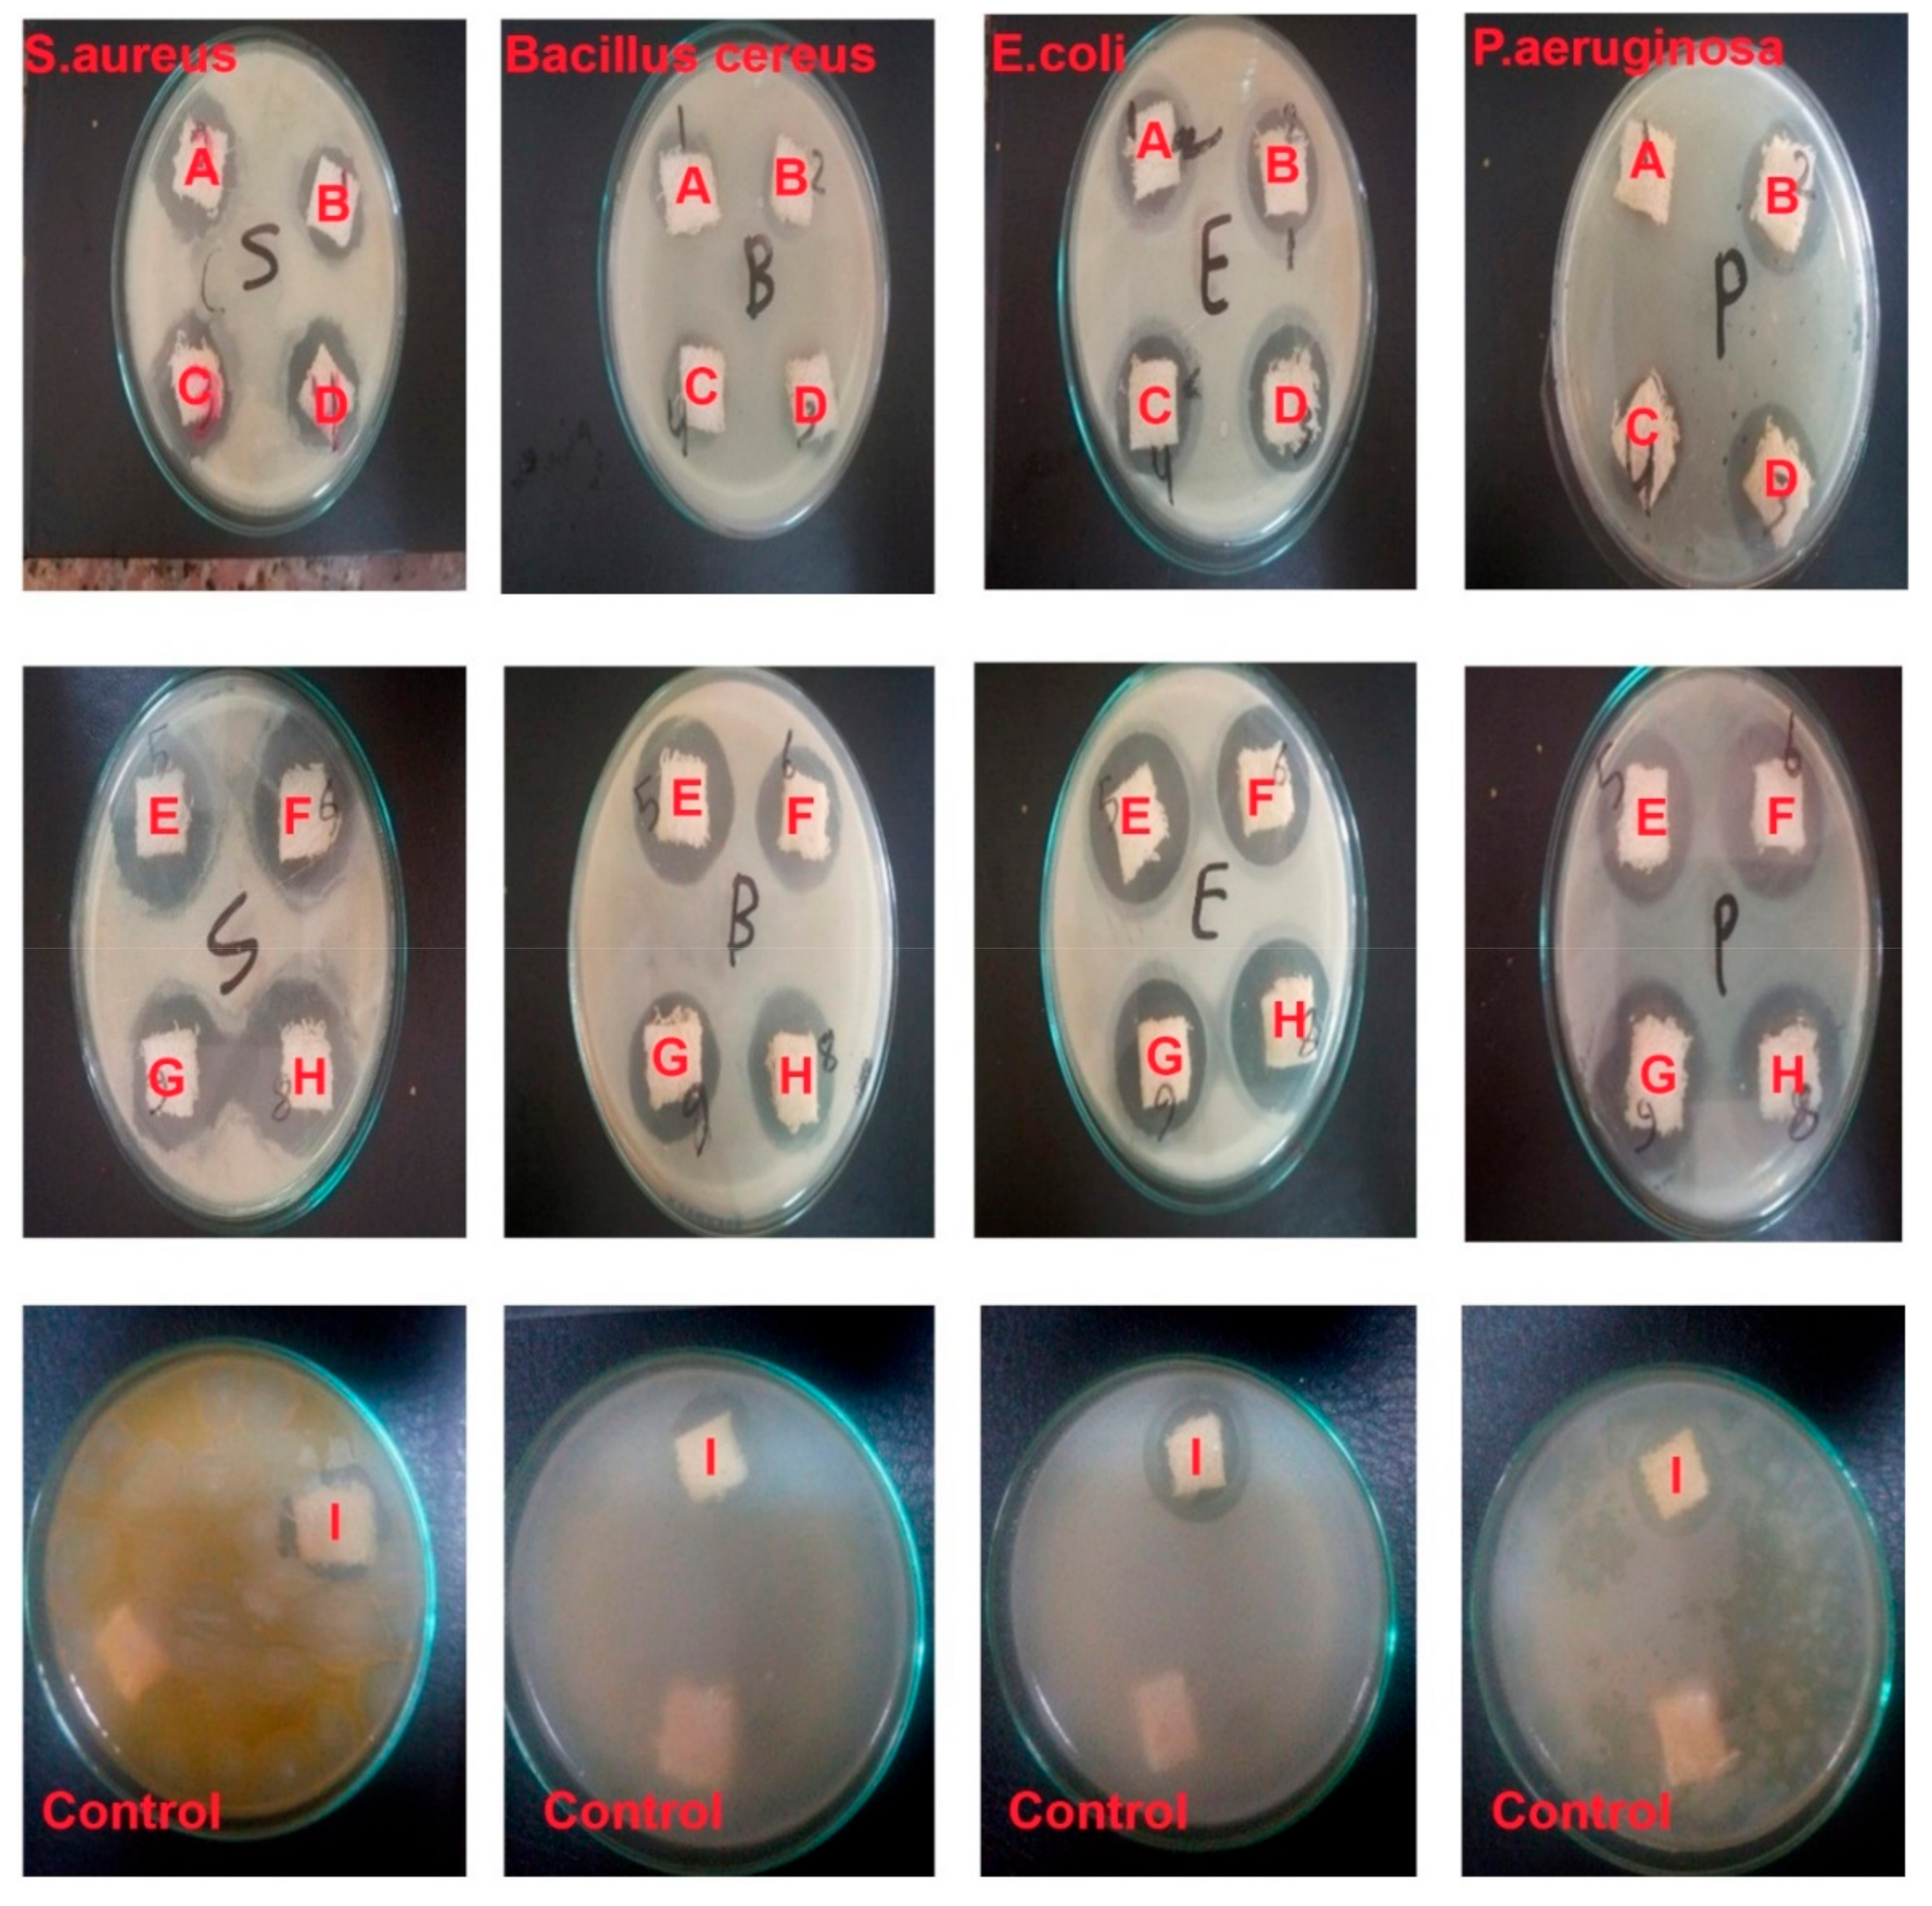
Polymers 13 02888 g006 550

Fabrication of New Multifunctional Cotton/Lycra Composites Protective Textiles through Deposition of Nano Silica Coating
Abstract
:1. Introduction
2. Materials and Methods
2.1. Fabric
2.2. Chemicals
2.3. Preparation of Silica Nanoparticles (SiO2 NPs)
Dynamic Light Scattering (DLS) and Zeta Potential Analysis
2.4. Treatment of Fabric with SiO2 NPs
2.5. Characterization and Functional Properties of Fabrics Treated with Metal NPs
2.5.1. Scanning Electron Microscopy (SEM) Analysis
2.5.2. Antibacterial Activity
2.5.3. UV Protection Properties
2.5.4. Self-Cleaning
3. Results and Discussion
- Weft material: Cotton/lycra of six samples: three samples (90.8% cotton and 9.2% lycra), three samples (95.5% cotton and 5.5% lycra), and three cotton samples for the standard comparative.
- Pile density: 15, 19, 22 picks/cm.
3.1. Characterization of Metal NPs Fabrics
3.1.1. SEM and EDX Analysis
3.1.2. Antibacterial Activity of Blank and SiO2-NP/Cotton/Lycra Composite Fabrics
3.1.3. UV Protection of Blank and SiO2-NP/Cotton/Lycra Composite Fabrics
3.1.4. Self-Cleaning of Blank and SiO2-NP–Cotton/Lycra Composite Fabrics
4. Conclusions
Author Contributions
Funding
Institutional Review Board Statement
Informed Consent Statement
Data Availability Statement
Conflicts of Interest
References
- Toprak, T.; Anis, P. Textile industry’s environmental effects and approaching cleaner production and sustainability, an overview. J. Text. Eng. Fash. Technol. 2017, 2, 429–442. [Google Scholar] [CrossRef] [Green Version]
- Badr, A. Anti-microbial and durability characteristics of socks made of cotton and regenerated cellulosic. Alex. Eng. J. 2018, 57, 3367–3373. [Google Scholar] [CrossRef]
- Ibrahim, H.M.; Zaghloul, S.; Hashem, M.; El-Shafei, A. A green approach to improve the antibacterial properties of cellulose based fabrics using Moringa oleifera extract presence of silver nanoparticles. Cellulose 2021, 28, 549–564. [Google Scholar] [CrossRef]
- Mesfin, S.; Sampath, V.R. Investigation on Mechanical and Comfort Properties of Denim Woven Fabrics Made from Different Spandex Percentage for Sports Wear. Curr. Trends Fash. Technol. Text. Eng. 2021, 7, 49–61. [Google Scholar] [CrossRef]
- Alndijany, N. Evaluation of the comfort properties of pile fabrics. Int. Des. J. 2020, 10, 521–530. [Google Scholar] [CrossRef]
- Tomar, R. Handbook of Worsted Wool and Blended Suiting Process; Woodhead Publishing India Pvt. Ltd.: New Delhi, India, 2010. [Google Scholar] [CrossRef] [Green Version]
- Ahmed, M.; Morshed, M.; Farjana, S.; Ana, S. Fabrication of new multifunctional cotton–modal–recycled aramid blended protective textiles through deposition of a 3D-polymer coating: High fire retardant, water repellent and antibacterial properties. New J. Chem. 2020, 44, 12122–12133. [Google Scholar] [CrossRef]
- Singha, K. Analysis of Spandex/Cotton Elastomeric Properties Spinning and Applications. Int. J. Compos. Mater. 2012, 2, 11–16. [Google Scholar] [CrossRef]
- Kundu, S.; Chowdhary, U. Effect of fiber content on comfort properties of cotton/spandex, rayon/spandex, and polyester/spandex single jersey knitted fabrics. Int. J. Polym. Text. Eng. 2018, 5, 33–39. [Google Scholar] [CrossRef]
- Prakash, C. Established the Effect of Loop Length on Dimensional Stability of Single Jersey Knitted Fabric Made from Cotton/Lycra Core Spun Yarn. Indian J. Sci. Technol. 2010, 3, 287–289. [Google Scholar] [CrossRef]
- Abd-Elfattah, M.A.; Abou-Taleb, E.M.; Emara, A.I. Improving the performance of terry fabrics to be used as pilgrimage Clothes. Int. Des. J. 2020, 10, 397–413. [Google Scholar] [CrossRef]
- Slater, K. Protection of or by textiles from environmental damage, in Environmental Impact of Textiles-Production, Processes and Protection, United Kingdom. Text. Inst. 2003, 163–166. [Google Scholar] [CrossRef]
- Beenu, S.; Manisha, G.; Rani, A. Development of UV Protective Clothing for College Going Girls. Int. J. Curr. Microbiol. Appl. Sci. 2019, 8, 1614–1621. [Google Scholar] [CrossRef]
- Rildaa, Y.; Syukria, F.; Alifa, A.; Aziza, H.; Chandrenb, S.; Nurc, H. Self-cleaning TiO2-SiO2 clusters on cotton textiles prepared by dip-spin coating process. J. Teknol. Sci. Eng. 2016, 78, 113–120. [Google Scholar] [CrossRef] [Green Version]
- Sobha, K.; Surendranath, K.; Meena, V.; Jwala, T.K.; Swetha, N.; Latha, K.S.M. Emerging trends in nanobiotechnology. Biotechnol. Mol. Biol. Rev. 2010, 5, 1–12. [Google Scholar] [CrossRef]
- Abou Elmaaty, T.; Abdeldayem, S.; Ramadan, S.; Sayed-Ahmed, K.; Plutino, M. Coloration and Multi-Functionalization of Polypropylene Fabrics with Selenium Nanoparticles. Polymers 2021, 13, 2483. [Google Scholar] [CrossRef]
- Ibrahim, N.; Eid, B.; Abd El-Aziz, E.; Abou Elmaaty, T.; Ramadan, S. Loading of chitosan Nano metal oxide hybrids onto cotton/polyester fabrics to impart permanent and effective multifunctions. Int. J. Biol. Macromol. 2017, 105, 769–776. [Google Scholar] [CrossRef]
- Abou Elmaaty, T.; El-Nagare, K.; Raouf, S.; Abdelfattah, K.; El-Kadi, S.; Abdelazi, E. One-step green approach for functional printing and finishing of textiles using silver and gold NPs. RSC Adv. 2018, 8, 25546–25557. [Google Scholar] [CrossRef] [Green Version]
- Cuk, N.; Sala, M.; Gorjanc, M. Development of antibacterial and UV protective cotton fabrics using plant food waste and alien invasive plant extracts as reducing agents for the in-situ synthesis of silver nanoparticles. Cellulose 2021, 28, 3215–3233. [Google Scholar] [CrossRef]
- Attia, G.H.; Alyami, H.S.; Orabi, M.A.A.; Gaara, A.H.; El Raey, A.M. Antimicrobial activity of silver and zinc nanoparticles mediated by eggplant green calyx. Int. J. Pharmacol. 2020, 16, 236–243. [Google Scholar] [CrossRef] [Green Version]
- Filipic, J.; Glazar, D.; Jerebic, S.; Kenda, D.; Modic, A.; Roskar, B.; Vrhovski, I.; Stular, D.; Golja, B.; Smolej, S.; et al. Tailoring of antibacterial and UV protective cotton fabric by an in-situ synthesis of silver particles in the presence of a sol–gel matrix and sumac leaf extract. Tekstilec 2020, 63, 4–13. [Google Scholar] [CrossRef]
- Ahmad, S.; Fatma, A.; Manal, E.; Ghada, A.M. Applications of Nanotechnology and Advancements in Smart Wearable Textiles: An Overview. Egypt. J. Chem. 2020, 63, 2177–2184. [Google Scholar] [CrossRef]
- Zhang, Y.Y.; Xu, Q.B.; Fu, F.Y.; Liu, X.D. Durable antimicrobial cotton textiles modified with inorganic nanoparticles. Cellulose 2016, 23, 2791–2808. [Google Scholar] [CrossRef]
- Das, D.; Yang, Y.; Obrien, J.; Breznan, D.; Nimesh, S.; Bernatchez, S.; Hill, M.; Sayari, A.; Vincent, R.; Kumarathasan, P. Synthesis and physicochemical characterization of mesoporous SiO2 nanoparticles. J. Nanomater. 2014, 2014, 62. [Google Scholar] [CrossRef] [Green Version]
- Aya, R.; Abdel Rahim, A.; Amr, H.; El-Amir, M. Improving Performance and Functional Properties of Different Cotton Fabrics by Silicon Dioxide Nanoparticles. J. Eng. Sci. 2019, 4, 1–17. [Google Scholar] [CrossRef]
- Bae, G.Y.; Jeong, Y.G.; Min, B.G. Superhydrophobic PET fabrics achieved by silica nanoparticles and water-repellent agent. Fibers Polym. 2010, 11, 976–981. [Google Scholar] [CrossRef]
- Chakraborty, J.N.; Yashdeep, S. Comparative Performance of Synthesised Silica Nanoparticles for Enhanced Hydrophilic Properties on Cotton. Tekstilec 2019, 62, 278–287. [Google Scholar] [CrossRef]
- Smiechowicz, E.; Niekraszewicz, B.; Strzelinska, M.; Zielecka, M. Antibacterial fibers containing nanosilica with immobilized silver nanoparticles. AUTEX Res. J. 2020, 20, 441–448. [Google Scholar] [CrossRef]
- Riaz, S.; Ashraf, M.; Hussain, T.; Hussain, M.T. Modification of silica nanoparticles to develop highly durable superhydrophobic and antibacterial cotton fabrics. Cellulose 2019, 26, 5159–5175. [Google Scholar] [CrossRef]
- Abbas, R.; Khereby, M.A.; Sadik, W.A.; El Demerdash, A.M. Fabrication of durable and cost effective superhydrophobic cotton textiles via simple one step process. Cellulose 2015, 22, 887–896. [Google Scholar] [CrossRef]
- Maurice, A.R.; Faouzi, H. Synthesis and characterization of amorphous silica nanoparitcles from aqueous silicates using cationic surfactants. J. Met. Mater. Miner. 2014, 24, 37–42. [Google Scholar] [CrossRef]
- Abou Elmaaty, T.; Elsisi, H.; Negm, E.; Ayad, S.; Sofan, M. Novel Nano Silica Assisted Synthesis of Azo pyrazole for the Sustainable Dyeing and Antimicrobial Finishing of Cotton Fabrics in Supercritical Carbon Dioxide. J. Supercrit. Fluid 2021, in press. [Google Scholar]
- Feifel, S.C.; Lisdat, F. Silica nanoparticles for the layer-by-layer assembly of fully electro-active cytochrome c multilayers. J. Nanobiotechnol. 2017, 9–59. [Google Scholar] [CrossRef] [PubMed] [Green Version]
- Ruiz-Cañas, M.C.; Corredor, L.M.; Quintero, H.I.; Manrique, E.; Bohórquez, A.R.R. Morphological and Structural Properties of Amino-Functionalized Fumed Nanosilica and Its Comparison with Nanoparticles Obtained by Modified Stöber Method. Molecules 2020, 25, 2868. [Google Scholar] [CrossRef]
- Abou Elmaaty, T.; Kasem, A.; Mona Elsalamony, M.; Hanan, E. A Green Approach for One Step Dyeing and Finishing of Wool Fabric with Natural Pigment Extracted from Streptomyces Thinghirensis. Egypt. J. Chem. 2020, 63, 1999–2008. [Google Scholar] [CrossRef]
- Masadeh, M.M.; Alzoubi, K.H.; Khabour, O.F.; Al-Azzam, S.I. Ciprofloxacin-induced antibacterial activity is attenuated by phosphodiesterase inhibitors. Curr. Ther. Res. 2014, 77, 14–17. [Google Scholar] [CrossRef] [Green Version]
- Wang, L.; Chen Hu, C.; Shao, L. The antimicrobial activity of nanoparticles: Present situation and prospects for the future. Int. J. Nanomed. 2017, 12, 1227–1249. [Google Scholar] [CrossRef] [PubMed] [Green Version]

| Fabric Specification | Material | Density/cm | Count (Ne) | Application Method |
|---|---|---|---|---|
| Warp specification | For ground warp: cotton is used for nine samples For Pile warp: cotton is used for nine samples | 24 ends/cm (12 ground ends+12 pile ends) | 24/2 Ne for both ground and pile warp ends | Wire pile |
| Weft Specification | Cotton (100%): for samples (A, B, and C) Cotton/Lycra (90.8/9.2%): for samples (D, E, and F) Cotton/Lycra (95.5/5.5%): for samples (G, H, and I) | (15, 19, 22) picks/cm | 16/1 Ne |
| Type of Loom | Picanol Nova 600 |
|---|---|
| Manufacturing Country | Italy |
| Date of Manufacturing | 1996 |
| Reed count | 12 dent/cm |
| Denting | 2 Ends/Dent |
| Weft Insertion Device | Rapiers |
| Type of NPs | Sample No. | Zone of Inhibition in mm | |||||
|---|---|---|---|---|---|---|---|
| Gram Positive Bacteria | Gram Negative Bacteria | Mean | SD | ||||
| S. aureus | Bacillus cereus | E. coli | P. aeruginosa | ||||
| Untreated | 1 | 0 | 0 | 0 | 0 | 0 | 0 |
| Treated using SiO2 NPs | A | 22 | 13 | 21 | 5 | 15.25 | 7.93 |
| B | 28 | 12 | 24 | 20 | 21 | 6.83 | |
| C | 28 | 13 | 27 | 28 | 24 | 7.35 | |
| D | 25 | 21 | 21 | 15 | 20.5 | 4.12 | |
| E | 30 | 30 | 30 | 26 | 29 | 2.00 | |
| F | 29 | 26 | 30 | 29 | 28.5 | 1.73 | |
| G | 29 | 27 | 31 | 31 | 29.5 | 1.91 | |
| H | 28 | 25 | 27 | 29 | 27.25 | 1.71 | |
| I | 19 | 17 | 23 | 22 | 20.25 | 2.75 | |
| Control Ciprofloxacin as antibiotic | J | 21 | 22 | 26.7 | 23.3 | 23.25 | 2.49 |
| Sample | UPF Values |
|---|---|
| 100% Cotton | 30 |
| Untreated Cotton/Lycra (94.5/5.5%) 19 pick/cm | 464.9 |
| Treated Cotton/Lycra (94.5/5.5%) 19 pick/cm | 2690.4 |
| Untreated Cotton/Lycra (90.8/9.2%) 19 pick/cm | 666.7 |
| Treated Cotton/Lycra (90.8/9.2%) 19 pick/cm | 4676.8 |
| Sample | K/S Value Unexposed | SD | K/S Value Exposed | SD | SCC |
|---|---|---|---|---|---|
| Blank | 25.8 | 0.32 | 11.9 | 0.25 | 53.8 |
| Cotton/Lycra (94.5/5.5%) 19 pick/cm | 20.7 | 0.31 | 0.63 | 0.02 | 96.9 |
| Blank | 25.3 | 0.32 | 16.7 | 0.33 | 33.9 |
| Cotton/Lycra (90.8/9.2%) 19 pick/cm | 21.1 | 0.23 | 0.73 | 0.03 | 96.5 |
Publisher’s Note: MDPI stays neutral with regard to jurisdictional claims in published maps and institutional affiliations. |
© 2021 by the authors. Licensee MDPI, Basel, Switzerland. This article is an open access article distributed under the terms and conditions of the Creative Commons Attribution (CC BY) license (https://creativecommons.org/licenses/by/4.0/).
Share and Cite
Abou Elmaaty, T.; Elsisi, H.G.; Elsayad, G.M.; Elhadad, H.H.; Sayed-Ahmed, K.; Plutino, M.R. Fabrication of New Multifunctional Cotton/Lycra Composites Protective Textiles through Deposition of Nano Silica Coating. Polymers 2021, 13, 2888. https://doi.org/10.3390/polym13172888
Abou Elmaaty T, Elsisi HG, Elsayad GM, Elhadad HH, Sayed-Ahmed K, Plutino MR. Fabrication of New Multifunctional Cotton/Lycra Composites Protective Textiles through Deposition of Nano Silica Coating. Polymers. 2021; 13(17):2888. https://doi.org/10.3390/polym13172888
Chicago/Turabian StyleAbou Elmaaty, Tarek, Hanan G. Elsisi, Ghada M. Elsayad, Hagar H. Elhadad, Khaled Sayed-Ahmed, and Maria Rosaria Plutino. 2021. "Fabrication of New Multifunctional Cotton/Lycra Composites Protective Textiles through Deposition of Nano Silica Coating" Polymers 13, no. 17: 2888. https://doi.org/10.3390/polym13172888
APA StyleAbou Elmaaty, T., Elsisi, H. G., Elsayad, G. M., Elhadad, H. H., Sayed-Ahmed, K., & Plutino, M. R. (2021). Fabrication of New Multifunctional Cotton/Lycra Composites Protective Textiles through Deposition of Nano Silica Coating. Polymers, 13(17), 2888. https://doi.org/10.3390/polym13172888

